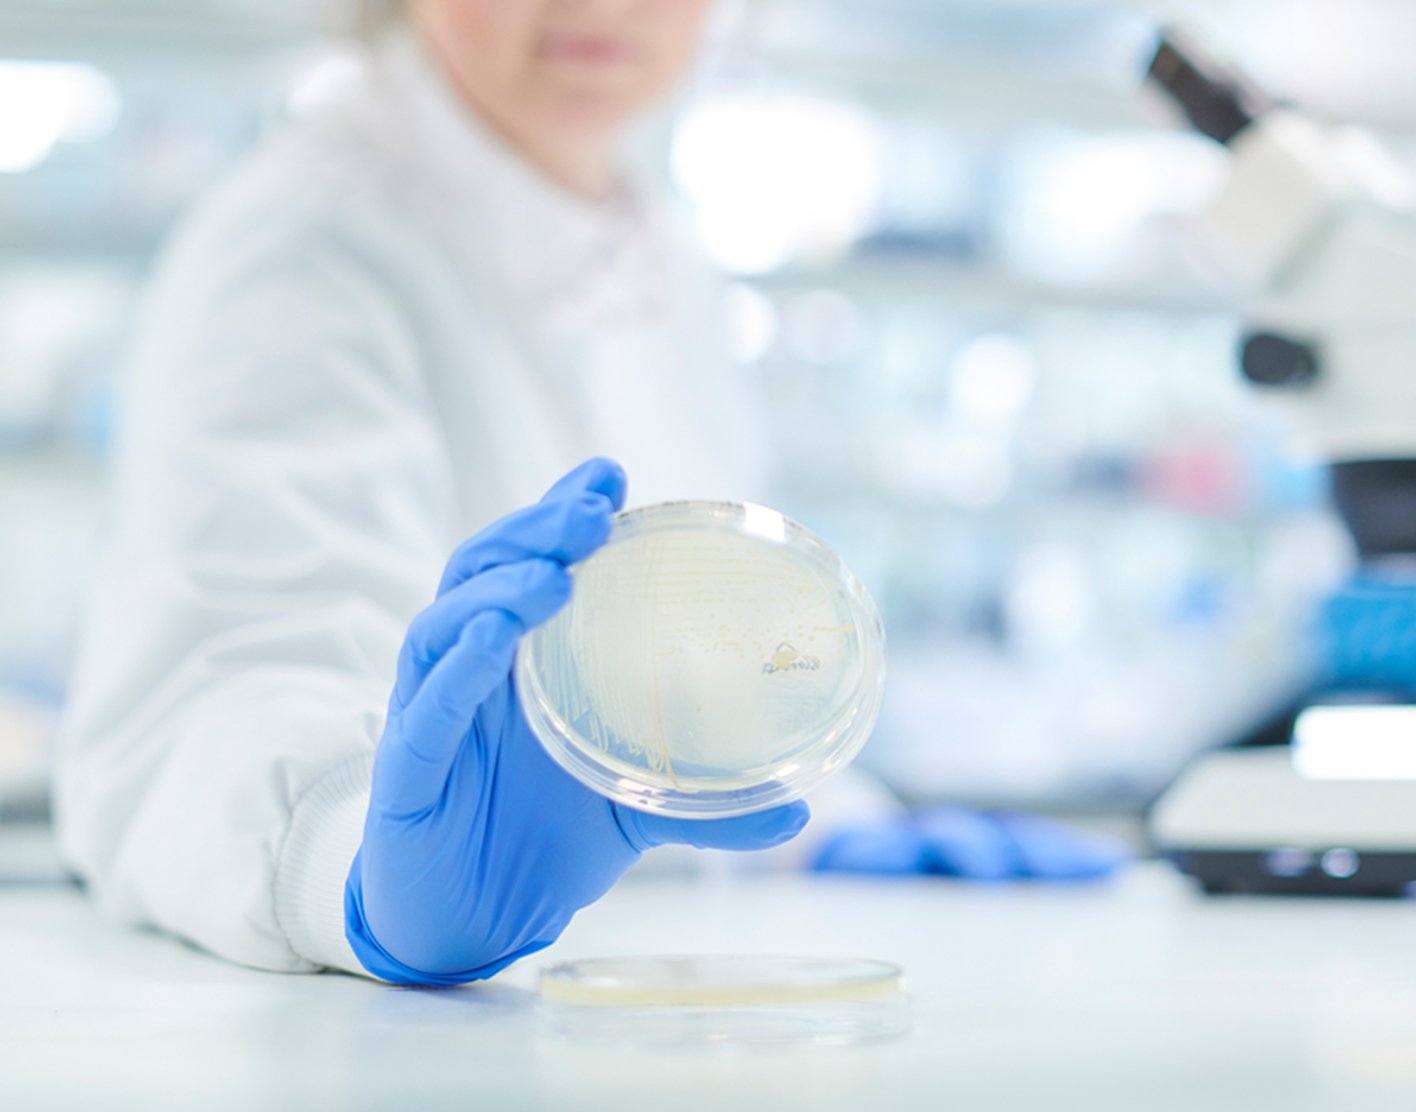

Stool guaiac test
Definition
The stool guaiac test looks for hidden (occult) blood in a stool sample. It can find blood even if you cannot see it yourself. It is a common type of fecal occult blood test (FOBT).
Guaiac is a substance from a plant that is used to coat the FOBT test cards to make them able to detect blood.
Alternative Names
Colon cancer - guaiac test; Colorectal cancer - guaiac test; gFOBT; Guaiac smear test; Fecal occult blood test - guaiac smear; Stool occult blood test - guaiac smear
How the Test is Performed
Usually, you collect a small sample of stool at home. Sometimes, your health care provider may collect a small amount of stool from you during a rectal examination.
If the test is done at home, you will use a test kit. Follow the kit instructions exactly. This ensures accurate results. In brief:
- You collect a stool sample from 3 different bowel movements.
- For each bowel movement, you smear a small amount of the stool on a card provided in the kit.
- You mail the card to a laboratory for testing.
Be sure to keep the stool away from any urine. Mixing of urine and stool can spoil the sample.
How to Prepare for the Test
Some foods can affect test results. Follow instructions about not eating certain foods before the test. These may include:
- Red meat
- Cantaloupe
- Uncooked broccoli
- Turnip
- Radish
- Horseradish
Some medicines may interfere with the test. These include vitamin C, aspirin, and NSAIDs such as ibuprofen and naproxen. Ask your provider if you need to stop taking these before the test. Never stop or change your medicine without first talking to your provider.
How the Test will Feel
The at-home test involves a normal bowel movement. There is no discomfort.
You may have some discomfort if the stool is collected during a rectal exam.
Why the Test is Performed
This test detects blood in the digestive tract. It may be done if:
- You are being screened or tested for
colon cancer . - You have abdominal pain, changes in bowel movements, or weight loss.
- You have
anemia (low blood count). - You say you have blood in the stool or black, tarry stools.
Normal Results
A negative test result means that there is no blood in the stool. Occasionally, this test will miss very small amounts of blood in the stool that is below the level of detection of this test (false negative).
What Abnormal Results Mean
Abnormal results may be due to problems that cause bleeding in the stomach or intestinal tract, including:
- Colon cancer or other gastrointestinal
tumors Colon polyps - Bleeding veins in the esophagus or stomach (
esophageal varices and portal hypertensive gastropathy) - Inflammation of the esophagus (
esophagitis ) - Inflammation of the stomach (
gastritis ) Hemorrhoids Crohn disease orulcerative colitis Peptic ulcer
Other causes of a positive test may include:
- Nosebleed
- Coughing up blood and then swallowing it
If the stool guaiac results come back positive for blood in the stool, your provider will likely recommend other tests, often including a
The stool guaiac test does not diagnose cancer. Screening tests such as colonoscopy can help detect cancer. The stool guaiac test and other screenings can catch colon cancer early, when it is easier to treat.
Risks
There can be false-positive and false-negative results.
Errors are reduced when you follow instructions during collection and avoid certain foods and medicines.
References
National Cancer Institute website. Colorectal cancer prevention (PDQ) - health professional version.
National Comprehensive Cancer Network website. NCCN clinical practice guidelines in oncology (NCCN guidelines): colorectal cancer screening. Version 1.2024 - February 27, 2027.
Patel SG, May FP, Anderson JC, et al. Updates on age to start and stop colorectal cancer screening: recommendations from the U.S. Multi-Society Task Force on colorectal cancer. Gastroenterology. 2022;162(1):285-299. PMID: 34794816
Savides TJ, Jensen DM. Gastrointestinal bleeding. In: Feldman M, Friedman LS, Brandt LJ, eds. Sleisenger and Fordtran's Gastrointestinal and Liver Disease. 11th ed. Philadelphia, PA: Elsevier; 2021:chap 20.
US Preventive Services Task Force website. Final recommendation statement. Colorectal cancer: screening.
Review Date: 30/01/2023
The information provided herein should not be used during any medical emergency or for the diagnosis or treatment of any medical condition. A licensed physician should be consulted for diagnosis and treatment of any and all medical conditions. Call 911 for all medical emergencies. Links to other sites are provided for information only -- they do not constitute endorsements of those other sites. Copyright ©2019 A.D.A.M., Inc., as modified by University of California San Francisco. Any duplication or distribution of the information contained herein is strictly prohibited.
Information developed by A.D.A.M., Inc. regarding tests and test results may not directly correspond with information provided by UCSF Health. Please discuss with your doctor any questions or concerns you may have.